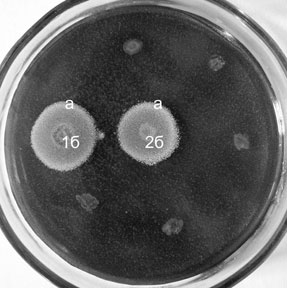
������� 1. �������������� ���������� ����������.

|
Будь здорова, Волга! |
|
Как мы уже сообщали, оренбургские микробиологи
директор Института клеточного и внутриклеточного симбиоза УрО РАН
член-корреспондент О.В. Бухарин и зав. лабораторией природных
микробиоценозов того же института доктор медицинских наук Н.В. Немцева в
составе авторского коллектива во главе с директором Института экологии
Волжского бассейна РАН (Тольятти) членом-корреспондентом Г. С. Розенбергом
стали лауреатами премии правительства РФ 2010 г. за разработку научных основ
и внедрение комплекса методов биомониторинга для устойчивого
эколого-экономического развития территорий Волжского бассейна.
Многокомпонентное исследование было выполнено специалистами разного профиля
из уже названного ИЭВБ РАН, а также Института проблем экологии и эволюции
им. А.Н. Северцова РАН (Москва), Нижегородского государственного
университета им. Н.И. Лобачевского, Института биологии развития им. Н.К.
Кольцова РАН (Москва). Сегодня мы рассказываем об этой актуальной работе
более подробно.
Площадь Волжского бассейна —1,36 миллиона
квадратных километров, что составляет 62% европейской части России. Здесь
проживает более 40% населения страны, которое производит 45% промышленной и
50% сельскохозяйственной продукции. Естественно, что сегодня качество воды в
Волге определяется не только многочисленными природными факторами, но и
антропогенными. Промышленные предприятия используют великую русскую реку в
качестве бесплатного приемника сточных вод — ежегодно в Волжский бассейн
сбрасывается до 20% всех сточных вод России, в атмосферу густонаселенных
городов Поволжья попадает почти 30% всех вредных веществ, выбрасываемых в
стране за год, и все это в конечном итоге опять же попадает в воду. На
территории Волжского бассейна произведено 26 «мирных» ядерных взрывов. Из-за
зарегулирования стока в результате строительства гидротехнических
сооружений, загрязнений, перепромысла объемы и качество уловов рыб в Волге
существенно снизились. Так, в районе Куйбышевского водохранилища в 1948–1950
гг. средняя годовая добыча рыбы составляла 22,8 тыс. центнеров, или около 24
кг/га водной поверхности. А в 2009 г. в этом водохранилище добыто всего 2,9
тыс. центнеров (2,6 кг/га) рыбы.
Волжский бассейн продолжает оставаться одним из
наиболее напряженных по экологической обстановке регионов. Его оздоровление
требует принятия эффективных управленческих решений. Как отмечают авторы
работы, удостоенной правительственной премии, предотвратить глобальные и
локальные экологические катастрофы, обеспечить устойчивое развитие
территорий и всей земной цивилизации можно только благодаря сохранению
средообразующей и ресурсной функций биоты.
Большинство экосистем способны функционировать
даже в условиях высокой антропогенной нагрузки. Однако, выполняя свою роль в
экосистеме, живые существа, в том числе и человек, могут быть серьезно
больны. Чтобы обозначить границы, за пределами которых наступят необратимые
изменения, необходимы методы биоиндикации и биомониторинга, позволяющие
отследить кумулятивное действие градиента-фактора (например, хронического
загрязнения водоема), оценить опасность воздействия на организм и экосистему
в целом, провести сравнение по степени опасности загрязнения (тяжелыми
металлами, пестицидами, радионуклидами).
Специалисты, составившие авторский коллектив,
сделали для этого очень многое. Они разработали экспертную информационную
систему REGION, позволившую провести комплексный анализ территорий Волжского
бассейна, новую систему комплексной оценки состояния здоровья среды по
нарушениям гомеостаза развития организмов — БИОТЕСТ, оригинальные
микробиологические методы оценки экологического состояния водных объектов,
теоретические основы и оригинальные экологические и поведенческие способы
защиты рыб от попадания и гибели в гидротехнических сооружениях,
концептуальную модель оценки риска инвазий чужеродных видов во внутренние
водоемы.
На основе предложенных учеными методов
Министерство природных ресурсов РФ утвердило ряд нормативных документов.
Паспортизированы городские озера Нижнего Новгорода и Тольятти, малые реки в
Самарской области. Пользованию программой БИОТЕСТ обучены сотрудники 20
заповедников страны.
Приведу некоторые цифры. Экономический эффект
от внедрения микробиологических методов оценки экологического состояния
водных объектов по Оренбургской области составил 127 миллионов рублей в год;
от использования новых методов биомониторинга для оценки ущерба водным
биоресурсам по Самарской области — 450 миллионов; от более рационального
использования паспортизированных городских озер Нижнего Новгорода — 2,8
миллиона рублей в год. Расчетная оценка экономического эффекта при
сокращении загрязнений воздуха и воды на 20% только от уменьшения временной
нетрудоспособности взрослого населения Волжского бассейна — 1,8–2 миллиардов
рублей в год.
Более подробно о микробиологической части
работы рассказал член-корреспондент РАН О.В. Бухарин:
— Наша задача — разработать микробиологические
подходы, позволяющие определять степень и качество загрязнения водоемов. Эти
исследования ведутся в нашем институте давно, в 2007 году вышла книга «Биоиндикация
экологического состояния равнинных рек». Сообщество гидробионтов, т.е.
водных обитателей, мы рассматриваем в рамках концепции ассоциативного
симбиоза. Этот «зоосад», как мы его называем, включает «хозяина», доминантов
и ассоциативную микрофлору. Прежде всего, нужно определить, кто в доме, в
данном случае в водоеме, хозяин. Так, в речном или озерном сообществе всегда
присутствуют водоросли, причем лидируют зеленые водоросли. Стоит их убрать,
распадется весь биоценоз. Например, если мы собираемся бороться с цветением
водоемов, то необходимо принять меры по поддержке зеленых водорослей.
Представители водной биоты связаны друг с
другом различными типами взаимодействий. Новые методические приемы оценки
симбиотических взаимоотношений гидробионтов позволяют выделять чистые
культуры водорослей, галофильных жгутиконосцев и
микроорганизмов-деструкторов, а также определять биологические свойства
водных обитателей. Мы предложили новые методы оценки экологического
состояния природных биоценозов, определения свежего фекального загрязнения и
использовали их для биоиндикации водоемов Волжского и Уральского бассейнов.
Казалось бы, оценить степень фекального загрязнения совсем несложно, надо
только определить уровень содержания в воде кишечной палочки. Однако в самой
воде ее может и не быть, в то время как в водоеме она присутствует. Кишечная
палочка умеет укрываться в слизистых чехлах водорослевых клеток или
локализоваться в клетках протист. Сохраняясь в клетках гидробионтов,
кишечная палочка ухудшает качество воды, делая ее опасной для здоровья
человека. Понимание симбиотических отношений в биоценозе позволяет более
точно оценить его экологическое состояние.
Нынешняя правительственная премия – вторая на
счету оренбургских микробиологов. В 2003 году сотрудники Института
клеточного и внутриклеточного симбиоза УрО РАН уже становились ее лауреатами
за разработку, организацию промышленного выпуска и внедрение в медицинскую
практику противовирусного препарата «Циклоферон». Эта работа продолжается и
сейчас, создаются комплексные препараты, где действующим началом является
«Циклоферон», эффективно стимулирующий защитные силы организма и подавляющий
персистентный потенциал микробов.
На фото:
О.В. Бухарин.
Н.В. Немцева.
Рисунок 1. Антилизоцимная активность
водорослей
Рисунок 2. Лизоцимная активность водорослей
Рисунок 3. Зеленые водоросли Pediastrum и Coelastrum.
|
|
НАУКА УРАЛА Газета Уральского отделения Российской академии наук Апрель 2011 г. № 08-09 (1036) |